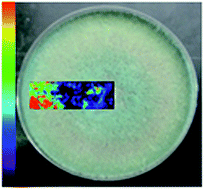

Mass spectrometry (MS) has become an important tool in microbiology for the identification of microorganisms and for monitoring the production of microbial secondary metabolites. Therefore, several ambient mass spectrometry techniques have been applied in the last few years. Although desorption electrospray ionization mass spectrometry (DESI-MS) is the most popular ambient MS technique, its application in the direct analysis of fungal compounds is still not well established. The irregular or uneven nature of the colony, the absorbent properties of the growth medium and the need for a firm surface for effective ionization hinder the direct screening of metabolites in fungal cultures by DESI-MS analysis. To overcome these limitations, in this study, we tested different surfaces, such as tape, porous polytetrafluoroethylene (PTFE), thin layer chromatography (TLC) surfaces, filter paper, flat silicon wafers and porous silicon (pSi), to obtain the best imprint-DESI-MS outcome with fungal cultures of Trichoderma harzianum for metabolite screening. We also evaluated the efficiency of the surfaces for the DESI-MS of small polar fungal metabolites in regard to signal intensity, signal stability and imaging suitability. The silicon surfaces provided the highest signal intensity for the fungal metabolites. PTFE and filter paper demonstrated relatively high signal stabilities that could be useful for prolonged DESI-MS/MS experiments, whereas tape was found to be the best option for DESI-MS imaging. The imprint on a tape surface was the only one capable of maintaining the structural features of the concentric conidial rings of T. harzianum.